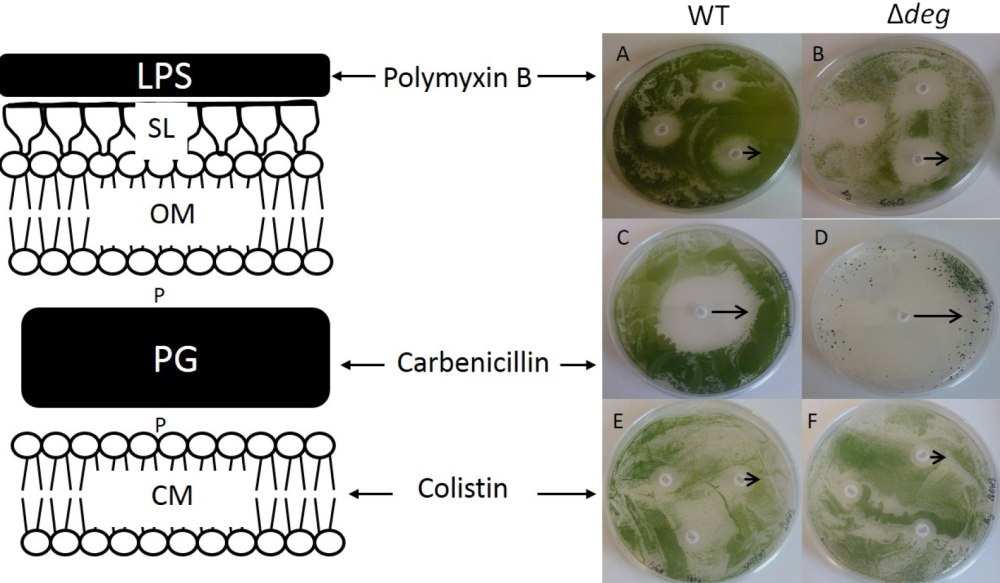

Полимиксии

---

Дексаметазон неомицин полимиксин


Полимиксин б

Полимиксины антибиотики препараты


Пластырь с антибиотиком

Синусэфрин

Safetec Triple antibiotic Ointment


Дексаметазон=неомицин=полимиксин препараты


Полимиксин структурная формула

Полимиксин в сульфат

Polymyxin b


Митоген ГАЗ

Bacitracin Neomycin Ointment

Неомицин полимиксин грамицидин

Полимиксин строение

Суролан ушные капли для собак


Bacterial membrane

Bio-Groom sure Clot кровоостанавливающая пудра 14,8 мл



Полиспорин мазь

Ушные капли для взрослых

Капли для глаз Таиланд


Дексаметазон неомицин полимиксин b




Ленточные бактерии

Дексапол капли глазные

Террамицин Пфайзер мазь

Полимиксии

Neosporin лекарство

Triple antibiotic мазь



Полимиксин б

Дексаметазон+неомицин+полимиксин b+фенилэфрин

Полимиксин и колистин


Полимиксин б

Полимиксин строение



Дексаметазон неомицин полимиксин в глазные капли

Полимиксин структурная формула








Полиспорин таблетки

Полимиксин формула химическая

Полимиксин структурная формула

Колистин в ветеринарии



Полимиксин структурная формула

Капли Суролан для собак

Арилмочевина



Неомицин сульфат + полимиксин

Polymyxin структура

Полимиксин в Джодас

Сефароза формула

Полимиксин и колистин



Мазь с тройным антибиотиком










